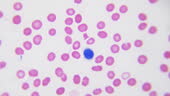
顕微鏡下での赤血球および白血球本社動画理科の授業固定および染色されたサンプル上のヒト血液成分の検査生化学実験室1000倍の倍率スムーズな

網赤血球(もうせっけっきゅう、英: Reticulocyte)は、赤芽球から細胞核が抜け落ちて出来たばかりの若い赤血球である。網状赤血球ともいう。
概要
赤芽球の最後の段階である正染性赤芽球は細胞核が抜け落ちて網赤血球となるが、細胞核が抜け落ちた時点では細胞質にリボソーム(ポリリボソーム)やミトコンドリアなどの細胞内小器官が残っている。網赤血球はまだ成熟赤血球のような真ん中がくぼんだ円盤状ではなく、残っているリボソームやミトコンドリアによってヘモグロビンの産出がつづいており、網赤血球の段階で10%-30%ほどのヘモグロビンが合成される。この若い赤血球はニューメチレンブルーによる超生体染色を行うとタンパク質とRNAの複合体であるリボソームがその他の細胞内小器官を巻き込みながら網状に凝集し、凝集したリボソームのRNAが青く染まり、顕微鏡観察では網状に見えるのでこの名前がある。網赤血球は骨髄内に2日ほど留まり、その後血液中に移動して1-2日ほどでリボソームやミトコンドリアが抜け落ちて成熟した赤血球になる。健康人では末梢血中の赤血球の0.5-1.5%ほどが網赤血球である。血中に多くみられる場合は、赤血球が壊れやすく寿命が短くなっている溶血性貧血や貧血治療の開始後あるいは高地への移住後まもなくなどで、骨髄での造血が盛んになっている状況があげられる。 逆に骨髄での造血機能がなんらかの理由で急速に衰えつつある状況では網赤血球は減少する。
脚注
参考文献
- 浅野茂隆、池田康夫、内山卓 監修『三輪血液病学』文光堂、2006年、ISBN 4-8306-1419-6、p120-124